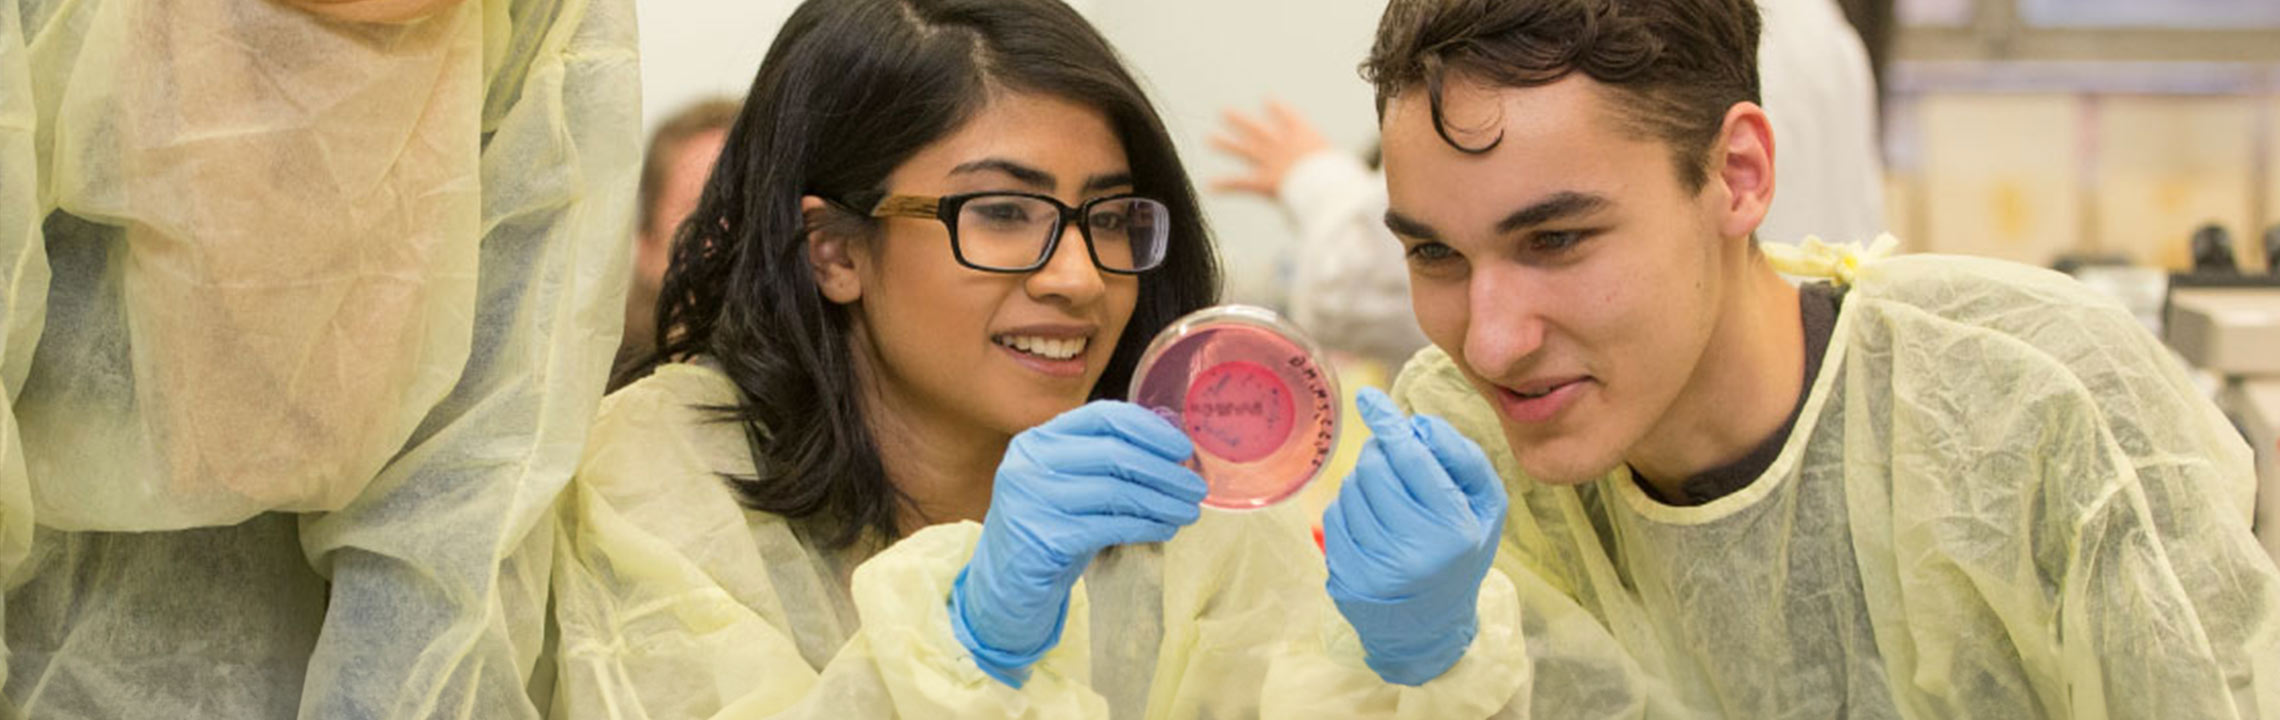

Public Health - BASc
Public Health - BASc
Degree: Bachelor of Applied Science
Faculty: Faculty of Community Services
Requirements: Grades-Only
Grade range: Low 70s1
Experiential learning: Co-op available
Full-time formats: 4 Year | 5-Year Co-op | 2-Year program for university graduates
Is this degree for you?

Public health professionals develop and implement initiatives that improve the health, safety and well-being of populations in the workplace, neighbourhoods, cities, countries and more.
The Public Health degree program offers experiential learning opportunities such as a paid co-op option, laboratory testing and analysis, site visits, presentations and seminars, and an independent research project. You’ll graduate prepared to protect the health of communities large and small and make a difference in the lives of many.
After graduation, you can become certified as an environmental health officer or public health inspector.
Accreditation:
- Canadian Institute of Public Health Inspectors
Student spotlight

“I completed three co-op work terms in different industries which allowed me to grow my network and gain valuable experiences beyond my studies.”
Zohal Mohamad Shafiq, Public Health, Class of 2024

After you graduate with this degree

🎓 Further education:
- Epidemiology
- Health administration
- International health
- Occupational and Public Health (MSc)
Career possibilities:
- Communicable disease investigator
- Epidemiologist
- Environmental health specialist
- Food safety auditor
- Public health advisor
💼 Employer possibilities:
- City of Toronto
- Halton Region
- Public Health Agency of Canada
- Public Health Ontario
- University Health Network (UHN)

Tuition and fees range 2024-2025
For detailed fees information, visit tuition and fees by program.

Full-time format:
Ontario students: $7,340 - $7,813
Out-of-province students: $8,402 - $9,101
International students: $35,063 - $36,374
First-year courses
Here is a preview of first-year courses based on the available undergraduate calendar information.
Faculty of Community Services
Toronto Metropolitan University's Faculty of Community Services offers a diversity of disciplines that focus on making a positive impact in the community. The rich curriculum of multi-disciplinary programs in health, education, social justice and community development is closely connected to the spirit and the dynamism of the community.
Faculty of Community Services degree programs
Thinking of applying? Make sure the program is still accepting applications.

This is a Grades-Only program. Admission decisions for Grades-Only programs are based on academic performance.
Ontario Secondary School Diploma (OSSD) or equivalent with a minimum of six Grade 12 U or M courses including the following program specific requirements.
Typically, a minimum overall average of 70% establishes eligibility for admission consideration; subject to competition individual programs may require higher prerequisite grades and/or higher overall averages:
- English/anglais (ENG4U/EAE4U preferred)
- One of Chemistry (SCH4U) or Biology (SBI4U)
- Note: the minimum grade(s) required in the subject prerequisites (normally in the 65-70% range) will be determined subject to competition
Note: Applicants with a Bachelor's Degree from an accredited university will not be considered for admission to the four-year degree program.
Academic admission requirements for all other applicants are available on the admission requirements page.
- Bachelor's degree or higher from an accredited university including three (lower or upper level) liberal studies courses.
- Applicants must have as part of their degree (or other post-secondary education) credit for at least one single-term course in chemistry (equivalent to CHY 104).
- Successful candidates may apply for up to six single-term transfer credits based on their previous university studies.

Subscribe for our email updates
Notice of Collection: Toronto Metropolitan University collects and manages personal information under the authority of the (PDF file) University Act and in accordance with the Notice of Collection for recruitment and other related purposes.


Notes:
- Actual minimum grade ranges required for fall 2025 admission/wait list consideration will be determined based on grades and qualifications presented by the applicant pool as they become available. Required grade ranges may fluctuate from year to year (up or down) as a result of competition. Applicants not educated in Ontario may present the equivalent of the Ontario requirements. TMU reserves the right to determine equivalency at its sole discretion.
Disclaimer:
While every effort is made to ensure accuracy on this site, in the event of a discrepancy, TMU's current Undergraduate Calendar is the official reference.